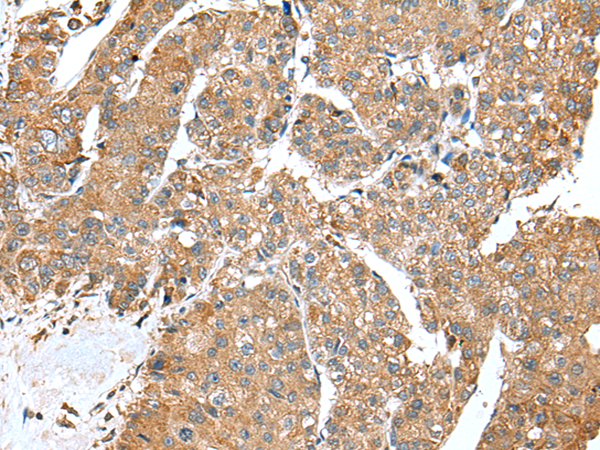
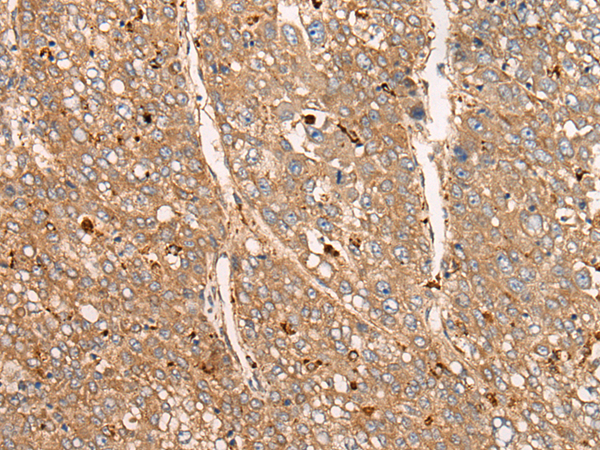

-
分类: 科研抗体货号: P04582别名: APXL; HSAPXL应用: IHC反应种属: Human
-
分类: 科研抗体货号: P04530别名: ACS3; FACL3; PRO2194应用: IHC反应种属: Human, Mouse, Rat
-
分类: 科研抗体货号: P04553别名: AARS; CMT2N; EIEE29应用: WB,IHC反应种属: Human, Rat
-
分类: 科研抗体货号: P04579别名: A3D; ARP6; APOBEC3E; APOBEC3DE应用: WB,IHC反应种属: Human
-
分类: 科研抗体货号: P04605别名: HIWI3应用: IHC反应种属: Human
-
分类: 科研抗体货号: P04550别名: HOT; ADH8; HMFT2263应用: IHC反应种属: Human, Mouse, Rat
-
分类: 科研抗体货号: P04576别名: BEDP; HEPR; CDAR1; APOBEC-1应用: IHC反应种属: Human
-
分类: 科研抗体货号: P04602别名: INT1; NET28应用: IHC反应种属: Human, Mouse
-
分类: 科研抗体货号: P04546别名: T1; ANT; AAC1; ANT1; PEO2; PEO3; ANT 1; PEOA2; MTDPS12; MTDPS12A应用: WB,IHC反应种属: Human, Mouse, Rat
-
分类: 科研抗体货号: P04570别名: AP-2B; AP2-B应用: WB反应种属: Human, Mouse

鄂公网安备42018502007531号
鄂公网安备42018502007531号

